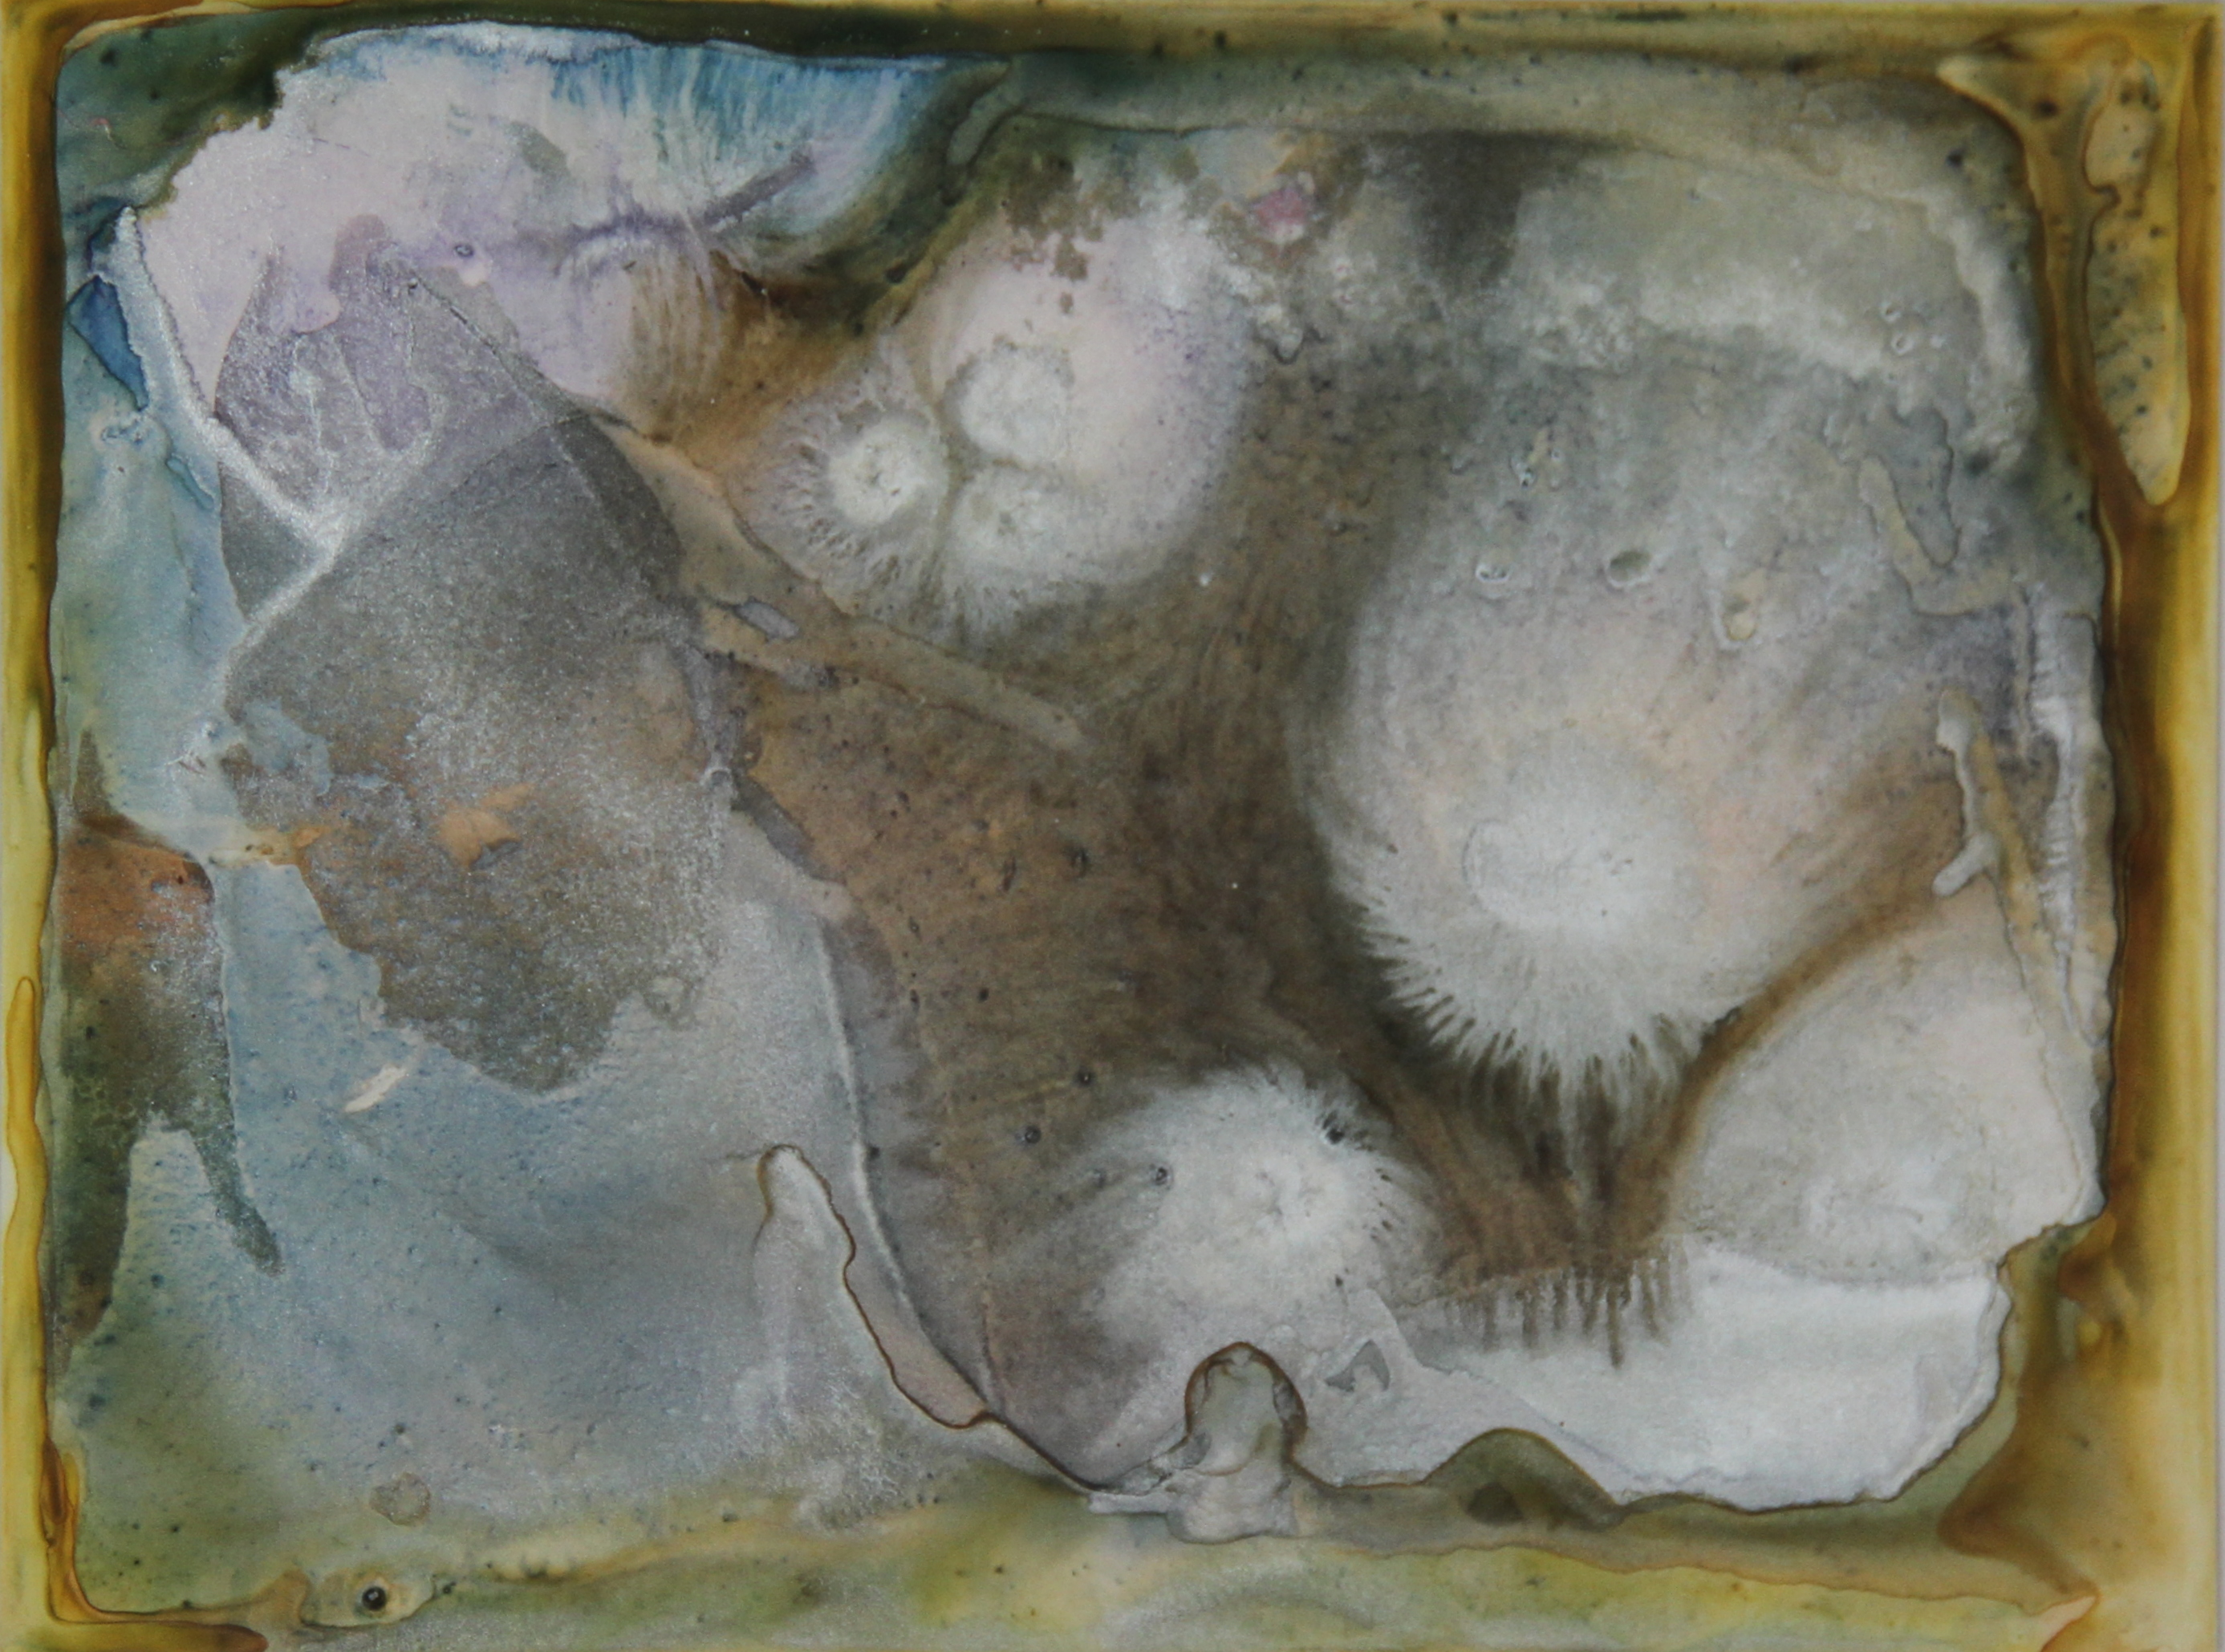

The Summer Drift series was completed over the two summers of 2014 and 2015. In this series, my focus was on the intimate and multi-faceted relationship between landscape, memory, and summer ritual. The series comes from exploration of the daydream-like state that is instigated by outdoor relaxation and warm weather, of being caught up in a pleasant environment and feeling at one with nature. By pushing this idea of unity further, the physical human body disappears to meld with and become another form in nature. Alien, yet familiar landscapes emerge.
The art in Summer Drift was made with watercolour & inks on YUPO, a synthetic paper. Thirty-four paintings were completed in total, comprised of 16 large (11 x 14″) and 18 small (9 x 12″). The paintings below represent just over one-half of the work.

Waterfall 
The Illumination of So Many Suns 
Eclipse 
Becoming Constellation 
Sea Foam
Ice 
Climate Change 
Wave I (Butterfly) 
Cave and Cloud

August Sky 
Marsh (Candy Floss) 
Steel I 
Sable Dore 
Further than Blue 
Vesuvio the Morning After 
Strange Trickling 
Steel II 
Vesuvio the Second Time